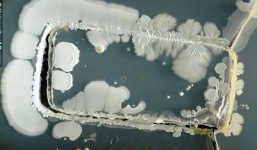
Rùng mình khi nhìn thấy 'thế giới' vi khuẩn trên dế yêu

Phiên bản Zenfone 5 giá rẻ hơn bất ngờ gia nhập thị trường
22-01-2015 | 09:03
Mới đây hãng điện tử Đài Loan lại bất ngờ tung ra một phiên bản mới của dòng Zenfone 5 tại quốc gia đông dân thứ hai thế giới này.

22-01-2015 | 08:50
Windows Phone 10 chính thức ra mắt, nhiều tính năng hấp dẫn

22-01-2015 | 08:24
Phát sốt với kính thực tế ảo HoloLens của Microsoft

21-01-2015 | 14:58
2014, năm đại thành công của Asus Zenfone 5

21-01-2015 | 13:58
HP ra mắt tablet màn "khủng" 12 inch kèm bút stylus

21-01-2015 | 13:38
Điện thoại thiết kế hình trái tim cho ngày lễ tình yêu

21-01-2015 | 10:26
Laptop mang thương hiệu Nokia liệu có được ủng hộ?

21-01-2015 | 10:22
Lumia 532: Smartphone giá rẻ đầu tiên chạy Windows Phone 10

21-01-2015 | 09:09
6 mẫu smartphone cấu hình cao cấp có giá thành tầm trung

21-01-2015 | 08:51
Chiêm ngưỡng tòa chung cư từ công nghệ in 3D đầu tiên trên thế giới

20-01-2015 | 15:38
Top 7 smartphone dưới 5 triệu đồng đáng mua

20-01-2015 | 14:29
LG trình làng laptop nhẹ nhất thế giới với trọng lượng bằng 3 quả táo

20-01-2015 | 14:07
Ngắm phiên bản BlackBerry mạ vàng đẳng cấp

20-01-2015 | 13:52
Smartphone giá rẻ có đèn flash mặt trước chính thức lên kệ

20-01-2015 | 08:28
Việt Nam đón Oppo N3 với cụm camera xoay cực kỳ lợi hại

19-01-2015 | 16:22
Chiêm ngưỡng YotaPhone 2 smartphone độc đáo 2 màn hình về Việt Nam

19-01-2015 | 15:45
Tổng hợp hình ảnh những chiếc gối độc đáo nhất thế giới

19-01-2015 | 14:02
Tốc độ internet Việt Nam "đội sổ" khu vực Châu Á

19-01-2015 | 11:02
Cận cảnh đồng hồ Thụy Sỹ phiên bản Trường Sa, Hoàng Sa

19-01-2015 | 10:50
Những câu chuyện giờ mới tiết lộ phía sau giới nhiếp ảnh ẩm thực

19-01-2015 | 10:30
Trò chuyện như trong phim khoa học viễn tưởng nhờ mạng 5G

19-01-2015 | 10:03
Loài nhện hiếm nhất thế giới có nguy cơ bị tuyệt chủng
19-01-2015 | 09:49
Rùng mình khi nhìn thấy "thế giới" vi khuẩn trên dế yêu

19-01-2015 | 09:25
Chiêm ngưỡng vẻ đẹp khó cưỡng của mẫu smartphone HTC Hima Ace

19-01-2015 | 08:38
Hé lộ 6 bí ẩn sẽ có trên iPhone 6S

17-01-2015 | 09:14
Sốc khi nhìn bảng lương của nhân viên Facebook

17-01-2015 | 08:47
Xuất hiện bằng chứng đắt giá về việc siêu phẩm Xperia Z4 ra mắt

16-01-2015 | 16:10
Chiều mai, sợi cáp AAG đầu tiên sẽ được nối lại

16-01-2015 | 14:12
"Apple Trung Quốc" tung phablet đối đầu iPhone 6 Plus

16-01-2015 | 11:14
Sony tuyên bố đóng cửa 14 cửa hàng ở Canada

16-01-2015 | 10:53

